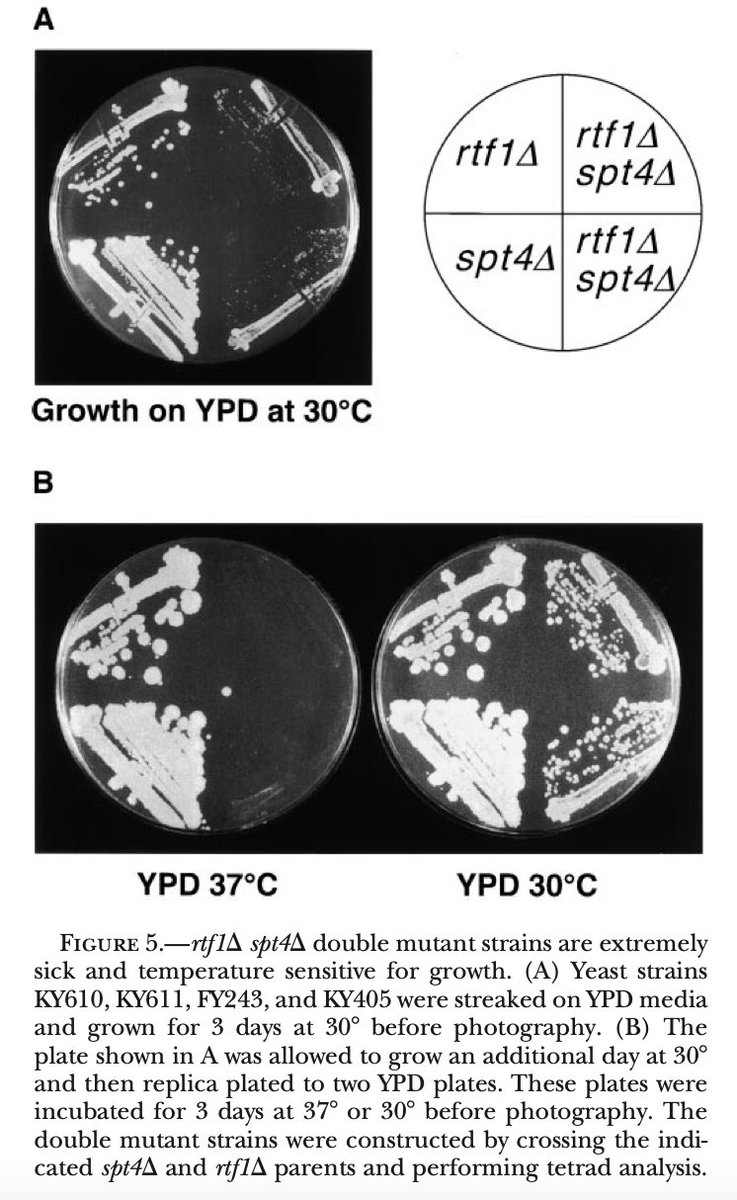
SusRodriguezNavarro tweet media

PafTheMagicDragon
138 posts


PafTheMagicDragon
@ArndtLab
In the Arndt lab, we are interested in transcription elongation control by the Paf1 complex. PI: Karen Arndt, University of Pittsburgh
Pittsburgh, PA Katılım Ağustos 2017
111 Takip Edilen339 Takipçiler

@TriggerLoop Same here. I was Peg: 15+, SLFs: 2 this afternoon. Seemed like a decent effort
English

@TriggerLoop Oh no. For real? (Peg here). Did they get you a backup?
English

@Rubenstein_Lab @chrstn_e @TrumanLab Actually, the @ArndtLab now uses a multi channel and 96 well Plates, and then plates using a frogger: Sigma R2383. Expensive, but huge time saver. We scan plates with an Epson scanner. Perfection V600 photo. Also very old
English

@KevinDKohl Uh, Edge, Firefox and Chrome all have that option too. Which I exploit at every power outage with my windows desktop (peg) (yes, I need to get a battery backup!)
English

@HainerLab @MTLeeLab Thanks. The one shelf here and there was what I was trying to avoid. And we already have stuff in @MTLeeLab that I've been waiting to move out once we got ours cleaned. 26 years of strains etc just adds up (and we have old JM stuff)
English

@susaopina @chrstn_e @yeast_papers To the best of my knowledge, we have not worked with W303 and this deletion. Following...
English

Does anyone know whether RTF1 deletion is dead or very sick at 37ºC in the W303 background? It's ts- in some backgrounds, but I'm not sure about W303 @ArndtLab @chrstn_e @yeast_papers
English

@chrstn_e Fragile Nucleosome alone, impacted so many, especially early in the pandemic. Add in all the undergrads you mentored so far... and your scientific contributions. I hope you are proud of what you accomplished so far. I look forward to watching you continue to succeed-peg
English
PafTheMagicDragon retweetledi

Looking forward! Two amazing stories about chromatin&transcription in yeast, one of them from my friend and #FragileNucleosome co-organizer @chrstn_e, what more could I want!
Ben Martin@bmart87
Registration is now open for next week's #FragileNucleosome Seminar, featuring @chrstn_e and @vanWervenlab! Join us for talks on RSC priming the quiescent genome for hypertranscription and Noncoding transcription, chromatin states and cell fate control! essex-university.zoom.us/webinar/regist…
English

@TriggerLoop That tweet was tagged and removed. Glad I missed it (peg)
English

@chrstn_e Just never answer with "yes?" Scammer alert (but on the other hand, who answers unknown numbers?!). I now go with.. "uh huh?" (Peg)
English

@BoyleLab Yes! Same thing I noticed in Regent Square. And... MASKS! (Peg)
English

@jengoefried Lots of noise in my neighborhood (peg), dogs, horns shouting
English

@yeastychic @McMurraylab I was training a new person on the dissection scope. A whole new experience with Covid distancing and precautions! (Peg)
English
PafTheMagicDragon retweetledi

Please retweet! Pitt BioSci is hosting a Virtual Open House on Nov 6, 4pm EST, for folks interested in applying to the EE or MCDB Ph.D. programs. Register here - biology.pitt.edu/graduate/how-a…

English

@reeselabpsu1 @YSPTSPS Under appreciated by the younger crowd (peg)
English



